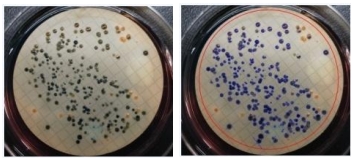
47e00829a53a3b9235080e418b9fbf08.png

The microbial detection and counting instrument is a rapid testing device that directly reads the results of enzyme substrate detection. It is suitable for the rapid enzyme substrate detection of total coliform, fecal coliform, Escherichia coli, aerobic plate count, enterococci and Pseudomonas aeruginosa.
It is also equipped with an automatic counting function for the aerobic plate count method and membrane filter method, enabling accurate recording and storage of each test result. Adopting an integrated computer-instrument design and supporting touch-screen operation, the instrument saves valuable laboratory space while improving work efficiency.
Equipped with an ultra-high-definition camera, it can capture and store high-quality images of each test result for record-keeping.

Product Advantages:
Automatic counting for 51-well quantitative plates
Automatic counting for 97-well quantitative plates
Automatic counting for 84-well quantitative plates
Automatic counting for petri dishes
Automatic counting for filter membranes
Generation of inspection reports
Effect Demonstration
51-well total coliform count before
51-well total coliform count after


97-well total coliform count before
97-well total coliform count after


84-well quantitative plate count before and after

Petri dish count before and after
Automatic filter membrane counting

(1) MFC Medium - Fecal Coliform Filter Membrane Method: Before and After Counting
(2) 3M Rapid Test Filter Membrane Method: Before and After Counting
Product Features:
(1) Countable Items: Total Colony Count, Total Coliforms, Fecal Coliforms, Escherichia coli, Enterococcus, Pseudomonas aeruginosa, etc.
(2) Compatible Sample Types: 51/97-well quantitative plates, 84-well quantitative plates (exclusive for total colony count enzyme substrate method), 90mm petri dishes, 45mm filter membranes, etc.;
(3) Fluorescent Bacteria Detection: Supports detection of fluorescent bacteria such as Escherichia coli under 365nm UV light;
(4) Door: Self-closing drawer door;
(5) Sample Trays: Compatible with multiple sample types, including 51/97-well quantitative plates, 84-well quantitative plates (dedicated for total colony count enzyme substrate method), 90mm petri dishes, 45mm filter membranes, etc.;
(6) Data Interface: Dust-proof, independent USB 3.0 port.